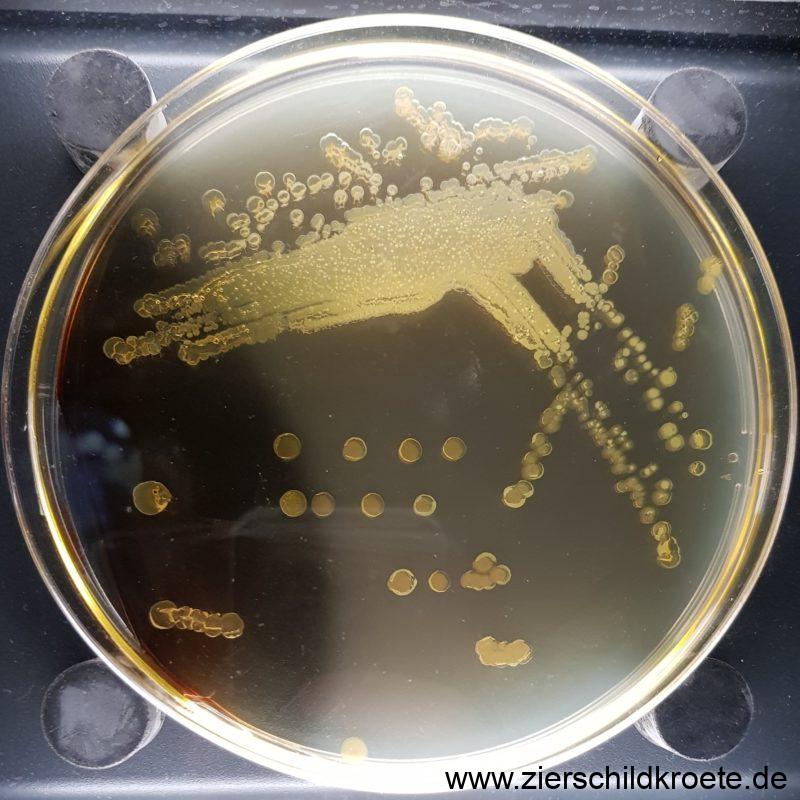

Salmonellen sind Bakterien die den Magen- und Darmtrakt verschiedener Tiere (der Mensch ist ja auch nur ein Tier ohne Fell) besiedeln und zu einer Krankheit mit dem Namen Salmonellose führen können. Man kann diese Erkrankung beim Menschen behandeln und keine Sorge, es wird dir so dreckig gehen, dass du freiwillig einen Arzt aufsuchst.
Zoonose
Eine Zoonose ist eine Krankheit die von Tieren auf den Menschen übergehen kann. Bei den Salmonellen handelt es sich um eine Zoonose. Die Salmonellen der Wasserschildkröten können also potentiell den Menschen infizieren. Klinisch werden die tausenden Salmonellen-Arten in drei Gruppen unterteilt: Typhus, Paratyphus und Gastroenteritis. Nur die letzte Gruppe, die Salmonellen die eine Gastroenteritis (also Entzündung von Magen und Dünndarm, sprich: Erbrechen und Durchfall mit Fieber) auslösen, sind als Zoonose von Bedeutung. Natürlich kann man von Reptilien Salmonellen bekommen, aber auch von vielen anderen Tierarten (Geflügel, Schweine, Rinder, Hund, Katze, Nager etc.). Auch über die Nahrung kann man Salmonellen aufnehmen, ohne Kontakt zu einem lebenden Tier gehabt zu haben. Zwei Drittel der Salmonelleninfektionen beim Menschen in Deutschland sind auf die Serovaren Salmonella Enteritidis (von Rindern, Nagetieren und vor allem Geflügel) und Salmonella Typhimurium (von Vögeln und Säugetieren) zurückzuführen. Beim Reptil kommen in der Regel andere Salmonellen-Serovare vor.
Wasserschildkröten und andere Reptilien können Träger und Ausscheider von Salmonellen sein ohne selbst daran zu erkranken!
Die Ansteckung erfolgt durch orale Aufnahme, also beispielsweise durch den Verzehr von salmonellenhaltigen tierischen Produkten, aber auch wenn man an einer Schildkröte leckt. Darüber hinaus sind Schmierinfektionen möglich, also wenn man beispielsweise ein Reptil mit Salmonellen angefasst hat und sich anschließend an oder in den Mund fasst.
Eine weitere bei Wasserschildkröten vorkommende Zoonose ist die Tuberkulose, auch sie kann vom Tier auf den Menschen übertragen werden.
Häufigkeit von Salmonellen bei Reptilien
In einer Untersuchung von BLAHAK et al. (2020) waren etwa ein Drittel aller Reptilien Träger von Salmonellen. Es gab jedoch deutliche Unterschiede bei den verschiedenen Gruppen, so waren 55 % aller Schlangen und 48 % aller Echsen positiv, aber nur 6 % aller Landschildkröten und 1 % der Wasserschildkröten. In anderen Untersuchungen waren Wasserschildkröten deutlich häufiger mit Salmonellen belastet. Zum Beispiel waren in japanischen Zoohandlungen fast 60 % der Rotwangen-Schmuckschildkröten Salmonellen-Träger (KUROKI et al. 2019).
Wie kann ich mich schützen?
Die gute Nachricht: in Deutschland steckt man sich selten von einem lebenden Tier aus mit Salmonellen an. Meistens sind die Erkrankungen auf den Verzehr von tierischen Lebensmitteln (Fleisch, Eier etc.) zurückzuführen die mit Salmonellen belastet waren.
Besonders gefährdet für eine Infektion mit Salmonellen sind die sogenannten YOPI (young, old, pregnant, immunosuppressed), also junge, alte, schwangere und immunsuppremierte Personen. Aber grundsätzlich sollte man sich angewöhnen nach jedem Kontakt mit einem Reptil bzw. nach einem Griff in das Aquarium bzw. Terrarium die Hände mit Seife gründlich zu waschen. Wer auf Nummer sicher gehen möchte, der desinfiziert sich sogar die Hände.
Die Reinigung aller Einrichtungsgegenstände, Filter und sonstiger Materialien darf keinesfalls in der Küche geschehen, um eine Kontamination der menschlichen Nahrung mit Salmonellen auszuschließen.
Säuglinge und Kleinkinder sollten keinen direkten Kontakt zu Reptilien haben. Die Reptilien dürfen auch keinen „Freilauf“ in der Wohnung haben, wenn es Kleinkinder gibt.
Der gesunde Menschenverstand sagt einem ja schon: Man darf weder an Schildkröten lecken noch sie in den Mund nehmen. Manchmal reicht gesunder Menschenverstand aber nicht, deshalb ist es in den USA verboten Schildkröten zu verkaufen die kleiner als 10 cm sind. Dieses 4 inch law wurde erlassen aus der Angst, dass kleine Kinder Schildkröten in den Mund nehmen und sich so mit Salmonellen infizieren.
Bei einem Wasserwechsel darf man keinesfalls das Wasser im Schlauch mit dem Mund ansaugen, da auch das Wasser mit Salmonellen belastet sein kann.
Diese Seiten sollen Ihnen nur als ersten Anhaltspunkt dienen wenn ihre Schildkröte krank sein sollte. Bitte versuchen Sie keinesfalls ihre Schildkröte selbst zu behandeln, dies kann sich nur zum Nachteil ihrer Schildkröte auswirken. Gehen Sie lieber einmal zu viel als zu wenig zu einem schildkrötenerfahrenen Tierarzt
Literatur
Blahak, S., S. Klees & B. Stührenberg (2020): Vorkommen und Häufigkeit von Salmonellen bei sezierten Reptilien im CVUA OWL in den Jahren 2015 bis 2019. – Postille des CVUA OWL, Nr. 221, S. 1-2.
Kuroki, T., T. Ishihara, N. Nakaijima, I. Furukawa & Y. Une (2019): Prevalence of Salmonella enterica subspecies enterica in Red-eared Sliders Trachemys scripta elegans retailed in pet shops in Japan. – Japan Journal of Infectious Diseases 23; 72(1): S. 38-43.